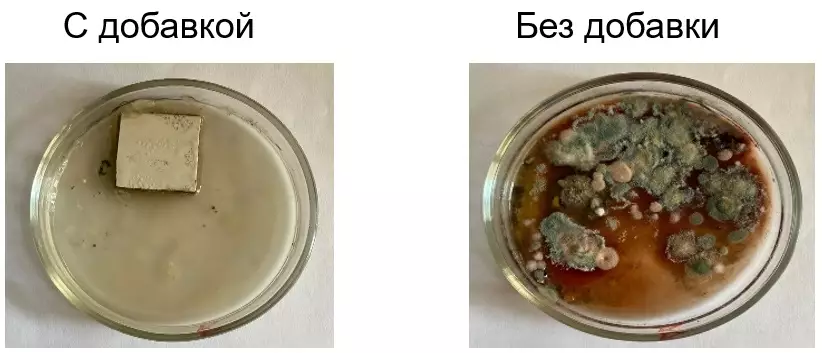

Научно-исследовательская деятельность
Приоритетными научными направлениями деятельности кафедры ПЭ являются:
- разработка экологически рационального способа утилизации шламов водоочистки;
- разработка энергосберегающих технологий переработки бытовых и промышленных отходов;
- исследование влияния микробиологического и физико-химических факторов на долговечность строительных материалов и прогнозирование их биокоррозионной устойчивости;
- мониторинг объектов окружающей среды;
- биотестирование объектов окружающей среды;
- разработка способов очистки сточных вод.
Кафедра имеет лицензию на работы, связанные с паспортизацией и инвентаризацией стоков, выбросов и отходов производства, разработкой проектов ПДВ и ПДС, проектов размещения отходов, контролем промстоков и хозяйственно-бытовой канализации, проектированием полигонов ТБО.
Учёные кафедры принимают активное участие практически во всех научно-практических конференциях, проходящих на территории Российской Федерации, а так же в странах ближнего и дальнего зарубежья. На конференциях, проводимых в БГТУ им. В.Г. Шухова, специально выделяется направление по профилю научной деятельности кафедры.
Студенты, обучающиеся по направлениям кафедры, успешно выступают с докладами на ежегодно проводимых в университете студенческих научных конференциях, а также на конференциях, проводимых в странах Ближнего Зарубежья. По результатам конференций студенты награждаются грамотами и различными призами.
Результаты научных исследований используются в учебном процессе при изучении таких специальных дисциплин, как «Промышленная экология», «Основы охраны вод», «ОВОС и экологическая экспертиза», «Техника защиты окружающей среды», «Технология переработки отходов».
Научные разработки сотрудников кафедры промышленной экологии БГТУ им. В. Г. Шухова
I. Переработка промышленных отходов и очистка сточных вод
На кафедре были получены:
-Сорбенты для очистки воды от нефтепродуктов, красителей, тяжелых металлов, жиров, СПАВ;
-Коагулянты для очистки от взвешенных веществ различного происхождения;
-Пигменты-наполнители для лакокрасочной промышлености, шпаклевок, замазок;
-Биоцидные покрытия для защиты строительных материалов и конструкций от биокоррозии;
-Строительные материалы с добавлением промышленных отходов.



Биоцидные добавки и покрытия
Имеются разработки по переработке и утилизации отходов горнодобывающей промышленности (хвостов обогащения, вскрышных пород, пылей, шламов), теплоэлектростанций, сахарной и маслоперерабатывающей промышленностей, целлюлозных отходов сельского хозяйства.
II. Рекультивация нарушенных почв
Сотрудники кафедры имеют опыт в рекультивации нарушенных территорий (свалок,карьеров, полигонов, городских территорий).
На кафедре получены патенты на органоминеральные удобрения и искусственные почвосмеси, разработанные на основе зоокомпоста личинки мухи Черной львинки, а также различных техногенных отходов. Органоминеральное удобрение отличается высокими показателями качества, которые обеспечивают стабильно высокие урожаи.

Искусственная почвосмесь обладает высокими показателями плодородия, которые обеспечивают повышение урожайности, может применяться в таких мероприятиях, как рекультивация нарушенных территорий, ландшафтный дизайн, оформление клумб и выращивание комнатных цветов.
Зоокомпост, входящий в состав органоминеральных удобрений, является эффективным стимулятором роста сельскохозяйственных культур и содержит важнейшие питательные компоненты.
За время работы кафедры были подготовлены и защищены следующие диссертации:
Латыпова, М.М. Регулирование агрегативной устойчивости минеральных суспензий органическими электролитами: диссертация на соискание степени кандидата химических наук по специальности 02.00.11 – коллоидная химия. Москва, 1998 г.
Порожнюк, Л.А. Очистка хромсодержащих стоков асбоцементных производств пылью электросталеплавильных цехов: диссертация на соискание степени кандидата технических наук по специальности 03.00.16 – экология. Белгород, 2001 г.
Старостина, И.В. Использование саморассыпающихся электросталеплавильных шлаков в технологии силикатных бетонов: диссертация на соискание степени кандидата технических наук по специальности 05.17.11 - технология силикатных и тугоплавких неметаллических материалов. Белгород, 2002 г.
Рубанов, Ю.К. Первичная переработка и использование саморассыпающихся электросталеплавильных шлаков в технологиях силикатных материалов: диссертация на соискание степени кандидата технических наук по специальности 05.17.11 - технология силикатных и тугоплавких неметаллических материалов. Белгород, 2003 г.
Василенко, Т.А. Очистка фосфатсодержащих сточных вод модифицированным шлаком электросталеплавильного производства: диссертация на соискание степени кандидата технических наук по специальности 03.00.16 – экология. Белгород, 2005 г.
Проскурина, И.И. Физико-химические закономерности процесса очистки медь- и никельсодержащих сточных вод шлаком электросталеплавильного производства: диссертация на соискание степени кандидата химических наук по специальности 02.00.04. – физическая химия. Белгород, 2007 г.
Свергузова, Ж.А. Получение и коллоидно-химические свойства сорбента на основе твердого отхода сахарной промышленности: диссертация на соискание степени кандидата технических наук по специальности 02.00.11 – коллоидная химия и физико-химическая механика. Белгород, 2008 г.
Дудина, С.Н. Повышение сорбционной способности природных глин электромагнитной активацией: диссертация на соискание степени кандидата технических наук по специальности 02.00.11 – коллоидная химия и физико-химическая механика. Белгород, 2008 г.
Свергузова, С.В. Комплексное обезвреживание сточных вод, утилизация осадков водоочистки и вторичное использование гипсо- и металлсодержащих промышленных отходов: диссертация на соискание степени доктора технических наук по специальности 03.00.16 – экология. Казань, 2008 г.
Благадырева, А.М. Очистка сточных вод от нефтепродуктов отходами сахарной промышленности: диссертация на соискание степени кандидата технических наук по специальности 03.00.16 – экология. Белгород, 2009 г.
Мтибаа Махмуд Гипсовое вяжущее на основе фосфогипса Туниса: диссертация на соискание степени кандидата технических наук по специальности 05.23.05 - строительные материалы и изделия. Белгород, 2009 г.
Кирюшина, Н.Ю. Очистка сточных вод гальванических производств от ионов Fe2+, Fe3+, Zn2+ электросталеплавильным шлаком: диссертация на соискание степени кандидата технических наук по специальности 03.02.08 – экология (по отраслям). Белгород, 2011 г.
Токач, Ю.Е. Технология переработки шламов гальванических производств и утилизации соединений тяжелых металлов: диссертация на соискание степени кандидата технических наук по специальности 05.17.01- технология неорганических веществ. Белгород, 2011 г.
Лупандина, Н.С. Очистка сточных вод от ионов тяжелых металлов отходами производства дисахаридов: диссертация на соискание степени кандидата технических наук по специальности 03.02.08 – экология (по отраслям). Белгород, 2012 г.
Флорес Ариас Мария Мелисса Разработка сорбента с магнитными свойствами на основе оксидов железа и отходов металлургического производства для ликвидации аварийных разливов нефтепродуктов: 02.00.11- коллоидная химия. Белгород, 2012 г.
Малахатка, Ю.Н. Коллоидно-химические особенности очистки сточных вод от ионов Fe3+, Fe2+, Zn2+ аспирационной пылью: диссертация на соискание степени кандидата технических наук по специальности 02.00.11 – коллоидная химия и физико-химическая механика. Белгород, 2012 г.
Ельников, Д.А. Очистка сточных вод от синтетических и органических красителей отходом производства дисахаридов: диссертация на соискание степени кандидата технических наук по специальности 03.02.08 – экология (в химии и нефтехимии). Пенза, 2013 г.
Фетисов, Д.Д. Утилизация нефтешламов и древесных опилок путем использования в производстве топливных брикетов: диссертация на соискание степени кандидата технических наук по специальности 03.02.08 – экология (в химии и нефтехимии). Пенза, 2013 г.
Тарасова, Г.И. Научные основы и методология комплексной переработки и утилизации многотоннажных кальцийкарбонат-, кальцийсульфат- и металлсодержащих отходов: диссертация на соискание степени доктора технических наук по специальности 03.02.08 – экология (в химии и нефтехимии). Иваново, 2014 г.
Фетисов, Р.О. Сорбционная очистка сточных вод от СПАВ отходом производства сахарной промышленности – сатурационным осадком: диссертация на соискание степени кандидата технических наук по специальности 03.02.08 – экология (в химии и нефтехимии). Белгород, 2015 г.
Гомес, М.Ж. Ультрафиолетовая (УФ) активация природных глин Ангольских месторождений для повышения их сорбционной активности в процессах водоочистки: диссертация на соискание степени кандидата технических наук по специальности 02.00.11- коллоидная химия и физико-химическая механика. Белгород, 2015 г.
Суханов, Е.В. Коллоидно-химические аспекты получения железосодержащего коагулянта-флокулянта на основе пыли электросталеплавильного производства: диссертация на соискание степени кандидата технических наук по специальности 02.00.11- коллоидная химия. Белгород, 2016 г.
Сапронова, Ж.А. Разработка комплексной технологии очистки сточных вод нефтехимических предприятий на основе активированных отходов сахарной промышленности на примере Белгородской области: диссертация на соискание ученой степени доктора технических наук по специальности 03.02.08 – Экология (в химии и нефтехимии). Уфа, 2016 г.
Шевага, О.Н. Разработка и исследование обратных эмульсий, стабилизированных термолизным карбонатсодержащим отходом: диссертация на соискание степени кандидата технических наук по специальности 02.00.11- коллоидная химия. Белгород, 2017 г.
Святченко А.В. Очистка поликомпонентных сточных вод с использованием реагентов на основе лигноцеллюлозных отходов и пыли электродуговых сталеплавильных печей. 1.5.15. Экология. ФГАОУ ВО «Пермский национальный исследовательский политехнический университет».
Спирин М.Н. Коллоидно-химические аспекты очистки сточных вод от растительных масел углекарбонатным сорбционным материалом по специальности 1.4.10. Коллоидная химия. Диссертационный совет 24.2.276.01 в Белгородском государственном технологическом университете им. В.Г. Шухова.